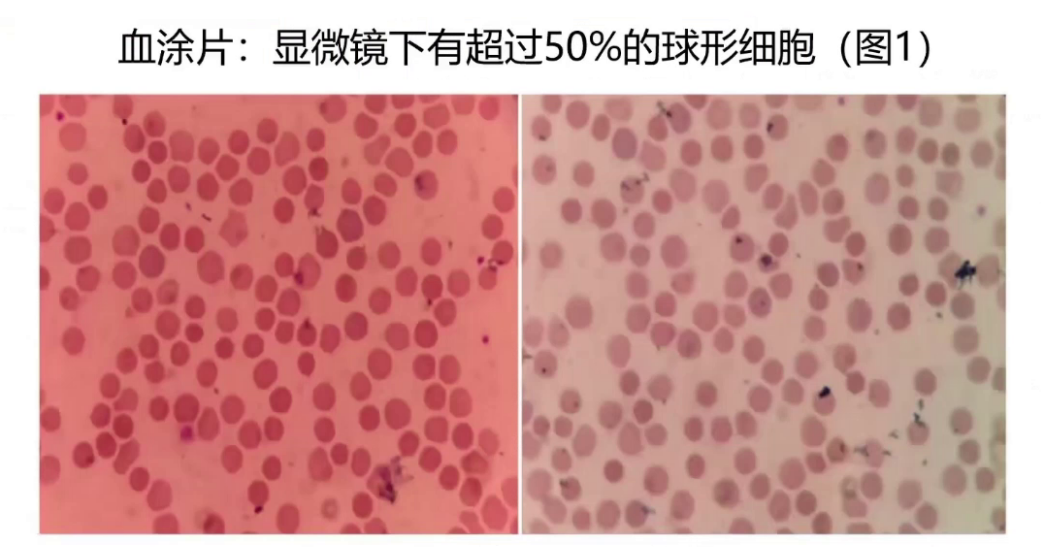
upfile 图片 6.png

查看更多
密码过期或已经不安全,请修改密码
修改密码
壹生身份认证协议书
同意
拒绝

同意
拒绝

同意
不同意并跳过





65岁男性患者,主诉发现血糖升高5年,双足麻木1年。
2018年3月患者无明显糖尿病症状,偶然查末梢血糖偏高,行OGTT检测,空腹血糖6.5mmol/L,0.5小时血糖11.79mmol/L,1小时和2小时血糖均高于11.1mmol/L,胰岛功能正常,糖化血红蛋白为5.5%,当时考虑血糖偏高但糖化血红蛋白正常,遂指导患者通过糖尿病饮食和运动控制血糖。2019-2022年患者无特殊不适,期间未系统监测血糖,偶有在2021年社区医院查空腹血糖7mmol/L,餐后2小时血糖11mmol/L,社区医院医生仍建议生活方式干预。至2023年,患者出现双足趾对称性麻木,当地卫生院复查空腹静脉血糖11mmol/L,糖化血红蛋白(HbA1c)6.0%,未予重视。2023年12月,双足麻木未缓解,就诊我院门诊,复查OGTT:空腹血糖12.2mmol/L,餐后2小时血糖25.2 mmol/L,HbA1c 5.6%,因血糖与HbA1c显著分离而收治入院。

既往有高血压、房颤病史,白内障术后。
吸烟40年,已戒烟3年。
母亲患有糖尿病。
查体:体重68kg,BMI 26.56kg/m²,提示轻度超重;心肺查体未见异常。专科检查示踝反射减弱,尼龙丝试验异常,振动觉减退。
实验室检查:

回顾患者2018年OGTT结果,0.5小时、1小时和2小时血糖均异常,虽当时糖化血红蛋白正常且无典型症状,但仍可明确糖尿病诊断,结合胰岛功能,考虑2型糖尿病可能性大。2023年再次行OGTT,空腹血糖超过7mmol/L,进一步支持糖尿病诊断。入院后检查糖尿病抗体均为阴性,无恶心呕吐等临床表现,血糖和血酮正常,OGTT提示胰岛功能良好,综合考虑2型糖尿病诊断明确。针对双足麻木症状,行神经肌电图检测,诊断为糖尿病周围神经病变。

采用皮下胰岛素降糖治疗,出院前血糖达目标范围。出院方案改为口服盐酸二甲双胍1g bid,西格列汀片5mg qd,达格列净5mg qd,并继续口服甲钴胺营养神经。
半个月后随访,患者末梢空腹和餐后血糖控制良好,糖化血红蛋白水平波动在5.7%-6.5%之间,静脉空腹血糖水平在6-6.8mmol/L。患者同时定期在血液科随诊。
1、血糖检测准确性?
在过去5年中,患者末梢血糖波动在9-20mmol/L,静脉血糖呈进行性升高,入院期间检测果糖胺水平也升高,且患者无急性疾病或应激等影响血糖波动因素,因此认为血糖检测准确。
2、糖化血红蛋白检测?
糖化血红蛋白是葡萄糖与血红蛋白β链末端缬氨酸氨基共价结合的稳定酮胺化合物,占总糖基化血红蛋白的60%,占人体血红蛋白总量的4%-6%,其数值取决于血糖浓度、血糖与血红蛋白接触时间及血红蛋白质量,反映测定前120天平均血糖水平,生物学变异较小。
糖化血红蛋白检测方法包括基于糖化与非糖化血红蛋白电荷性质不同的离子交换高效液相色谱法或毛细血管电泳法,以及基于分子结构不同的免疫分析法、酶法、硼酸亲和层析法。本病例采用国际指南和共识推荐的高效液相色谱法,且检测过程未提及血红蛋白变异体,故不考虑方法学干扰。
非方法学干扰因素分为导致假性糖化血红蛋白减少和升高两类,年龄和种族也会使糖化血红蛋白假性升高。因本例患者血糖偏高但糖化血红蛋白正常,故重点考虑导致假性糖化血红蛋白减少的因素,包括影响红细胞寿命的疾病(如溶血性贫血、失血、脾大、风湿性关节炎、慢性肝病等)、相关药物(如维生素C、维生素E抑制血红蛋白糖化)、妊娠(血容量增加导致假性减少)、进展迅速的1型糖尿病(不能反映急性血糖变化)、血脂高(影响血红蛋白检测)及血红蛋白变异体。

对该患者逐一鉴别上述因素,患者无特殊病史及药物使用史,血脂谱正常,既往无贫血病史,可排除药物、急性血糖变化、血脂、妊娠及失血因素。进一步检查血常规,虽白细胞、红细胞计数轻度减低,但血红蛋白133g/L处于正常范围,平均红细胞血红蛋白量和浓度正常偏高。然而,患者网织红细胞百分比高达6.22%,计数超过正常水平,提示骨髓造血活跃,直接胆红素和间接胆红素高于正常水平。虽血清铁、铁蛋白、血磷、肝酶和肾功能正常,腹部彩超仅提示脾大,排除慢性肝病,但综合考虑仍需进一步排查不典型溶血性贫血。
3、溶血性贫血鉴别?
溶血性贫血鉴别主要分原发性和继发性溶血,该患者无相关病史和药物史,除外继发性溶血,重点鉴别红细胞相关溶血疾病。

从血液学角度,采用血涂片、红细胞孵育渗透脆性试验、直接抗人球蛋白试验、血红蛋白变异体检测和血红蛋白H包涵体试验等进行鉴别。检查发现患者血涂片异常,超50%红细胞呈球形,而非正常双凹圆盘状,但红细胞孵育脆性试验阴性。进一步通过一氧化碳呼气试验检测红细胞寿命仅20天(参考范围超70天),高度怀疑遗传性球形红细胞增多症。

采用全外显子组测序,发现患者在HPTA1基因中存在错义插入突变,符合遗传性球形红细胞增多症Ⅲ型诊断。

综上所述,该患者为遗传性球形红细胞增多症,红细胞寿命短,导致血红蛋白糖基化时间不足/糖化血红蛋白破坏过多,导致患者高血糖被低估,糖尿病诊治被会“撒谎”的假性减少的糖化血红蛋白所延误。
4、临床应对静脉血糖与糖化血红蛋白不匹配
若在血红蛋白病高发地区,需考虑糖尿病筛查诊断及治疗并寻求血液科帮助。首先做血常规判断是否贫血,若贫血则至血液科做血红蛋白组分分析;若不贫血,需考虑其他影响因素,如妊娠、近期输血、使用促红细胞生成药物、反复低血糖等,同时了解糖化血红蛋白检测方法是否为推荐金标准。若存在其他因素,可考虑用多点血糖监测、动态血糖监测、糖化白蛋白等替代指标反映血糖水平。
遗传性球形红细胞增多症(hereditary spheroeytosis,HS)是常见的遗传性溶血性贫血,在欧美地区是慢性溶血性贫血的主要原因,我国发病率约十万分之一。临床特点为贫血、黄疸及脾大,临床表现异质性大,轻者无症状性贫血,重者可发生溶血,外周血红细胞渗透脆性增加伴基因突变,可遗传给后代。轻型患者骨髓代偿功能良好,可无或仅有轻度贫血及脾大,但网织红细胞计数和血清胆红素轻度升高,外周血涂片球形红细胞少见,因其症状不典型、发病率低,误诊和漏诊率高。其发病机制主要是基因突变(如HSPTA1、SPTB、ANK1、SLC4A1和SLC4A2等)导致红细胞膜蛋白异常,其中SPTB突变最为常见,外显子组检测技术可提高诊断率。
本病例中患者临床表现隐匿,无贫血但造血活跃,伴有脾大,携带的SPTB基因突变导致红细胞膜蛋白缺陷或异常,形成遗传性球形红细胞,红细胞寿命仅20天,远低于正常。
查看更多
专家点评
HbA1c作为评估长期血糖控制水平的“金标准”,其诊断价值已获广泛认可。国内外指南将其≥6.5%作为糖尿病的补充诊断标准,主要基于其与糖尿病微血管病变风险显著相关的循证依据。然而,HbA1c水平受多种因素影响,其中红细胞寿命和血红蛋白糖基化速率是关键。任何导致红细胞寿命缩短或延长的疾病,均可导致HbA1c与实际平均血糖水平出现偏差。
本病例所涉及的遗传性球形红细胞增多症,正是一种因红细胞膜蛋白基因缺陷导致红细胞球形变、在脾脏过早破坏的常染色体显性遗传性溶血性疾病。其临床表现异质性大,轻者可无症状,重者出现贫血、黄疸、脾肿大。本例患者直至老年才因血糖与HbA1c显著不符而被发现,且无典型贫血症状,凸显了该病在成人中表现的隐匿性,基因检测有助于明确诊断及家系筛查。
本例带来的核心启示在于,当临床遇到HbA1c与血糖水平明显不匹配时,必须主动排查是否存在影响红细胞寿命或血红蛋白糖基化的因素。尤其对于合并贫血(即使症状不典型)的糖尿病患者,HbA1c不宜作为血糖评估的可靠指标。此时应转向糖化白蛋白、动态血糖监测或多点血糖监测等替代方法,以实现对血糖水平的真实评估。在糖尿病诊疗中需保持辨析思维,对不典型的检验结果进行深入追溯,从而避免误诊漏诊,实现个体化精准管理。